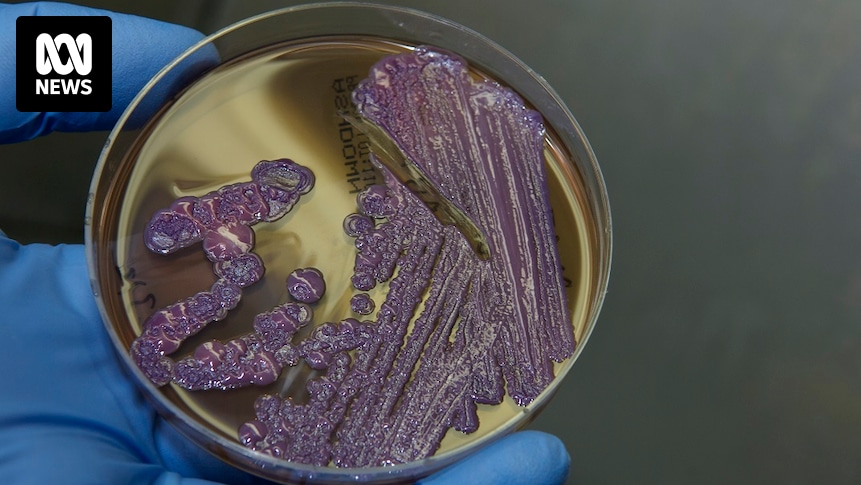

General
Two more deaths from soil-borne disease melioidosis recorded in Far North Queensland
Two more people have died from the soil-borne disease melioidosis in Far North Queensland.
Cairns and Hinterland Hospital and Health Service has recorded 41 cases of the illness, which is associated with soil and groundwater after heavy rain, since January 1.
Last week the health service revealed…
Continue Reading

